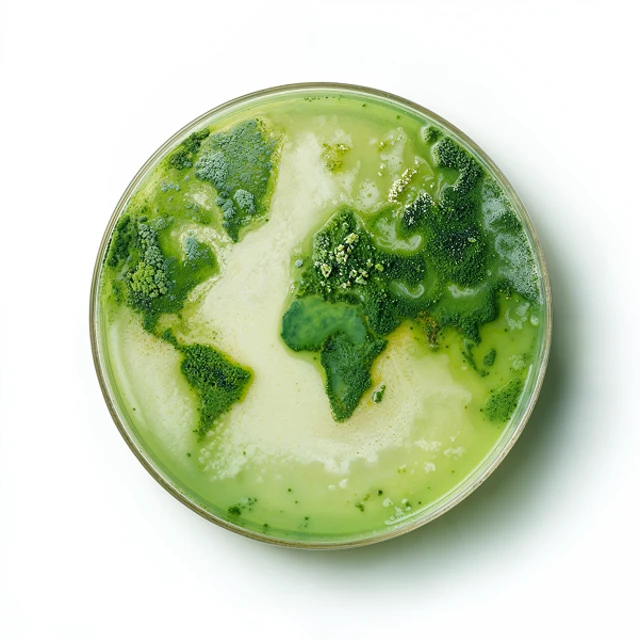
Petri

The economic growth story
of our time
It's time to ignite a global growth engine for a prosperous, climate-resilient future - and the technologies we need are here. Biosolutions alone are on track to deliver nearly $930 billion in global value by 2035, driving positive change for both our wallets and our planet. Find out how we forge this new growth era together.
How can we create
a healthier, more prosperous future?
The world is changing fast – and we’re all adapting. Shifting weather patterns and resource pressures are disrupting industries and reshaping the global economy. But adapting to change isn’t just a cost. It’s an investment in people, countries and communities – one that can tackle climate challenges while creating jobs and lasting prosperity.
The technologies to drive this transformation are here. Biosolutions alone could generate nearly $930 billion in value and 5 million jobs globally by 20351 – a clear signal of the opportunity ahead.
Read on to discover how biosolutions are powering the growth story of our time, where our economy and our planet thrive together.
Biosolutions open
new opportunities
for a new world
Biological solutions – or biosolutions – are reshaping industries across the globe, offering powerful answers to our most pressing challenges. These microbes, enzymes and other proteins not only help reduce waste, save energy and water, and lower dependence on fossil resources – they also create unique opportunities for both environmental and economic resilience.
From transforming agriculture with healthier soils and animals to advancing biofuel production to reinventing everyday products and systems, biosolutions are becoming central to effective climate mitigation and adaptation – while at the same time triggering new economic opportunities across the globe.
Biosolutions, and other innovative technologies, are laying the foundation for a thriving, climate-resilient economy.
What if we saw
change as opportunity?
We’re all adapting to a changing world. But what if we did more than adapt? By leaning into change using the technologies we already have, we can build an economy that works for everyone – and protects what matters most. Discover how. Watch the video below.
Explore biosolutions at work
for a climate-ready economy

Resilient agriculture
See how biosolutions help drive resilient, profitable farming with less climate impact.

Local energy and biofuels
Learn how biosolutions help make biofuel from plants, reducing CO2 and powering energy independence.

Industrial productivity
Find out how biosolutions help manufacturers cut energy and boost efficiency and profits - sustainably.

Better low-carbon products
Discover how biosolutions make climate-smart choices easier on consumers’ budgets.
Big change starts with
people coming together
When policymakers, business leaders, young voices and consumers join forces, we can build an economy where people and the planet thrive together. Curious how the next generation sees it? Hear from three young climate leaders on what it really takes to work together for a brighter future.
See how industry pioneers are shaping a more profitable future

Agrindus builds resilience right into the business
Agrindus, a dairy and beef producer near São Paulo, is turning resilient sustainable agriculture into a strategy for leadership and growth.

Fermap’s circular model fuels growth – on the farm and beyond
In central Brazil, bioenergy producer Fermap is going circular – to cut waste, grow profits, and strengthen the local economy.
Let’s ignite the next
global growth engine
A new report documents the current value of the global biosolutions sector and projects a boom in its future: it could generate nearly $930 billion and support 5 million jobs worldwide. But realizing this potential depends on the right policies and investments. Find out how you can help drive the biosolutions boom.
By 2035, biosolutions are projected to generate nearly $930 billion in economic value globally.1
This growth is expected to support 5 million jobs, both in the sector itself and across the value chain.1
We can build a new economy that’s aligned with climate goals and drives lasting economic prosperity.